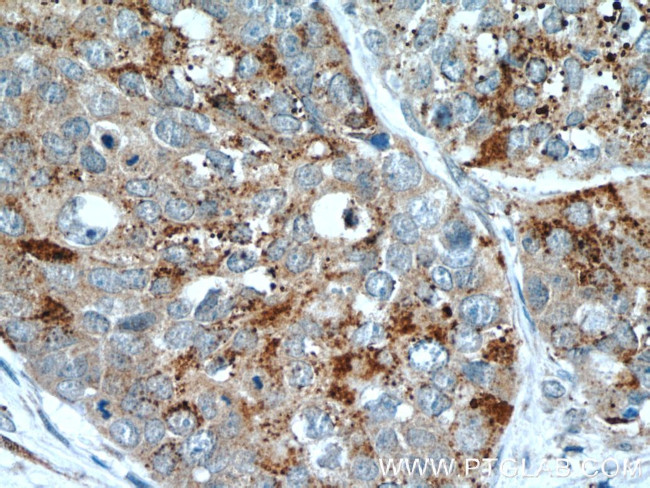
HDAC4 Antibody in Immunohistochemistry (Paraffin) (IHC (P))

Search
Proteintech
HDAC4 Polyclonal Antibody
{{$productOrderCtrl.translations['antibody.pdp.commerceCard.promotion.promotions']}}
{{$productOrderCtrl.translations['antibody.pdp.commerceCard.promotion.viewpromo']}}
{{$productOrderCtrl.translations['antibody.pdp.commerceCard.promotion.promocode']}}: {{promo.promoCode}} {{promo.promoTitle}} {{promo.promoDescription}}. {{$productOrderCtrl.translations['antibody.pdp.commerceCard.promotion.learnmore']}}














Please note: We are reviewing Western blot images included in the antibody testing data in our catalog, including those provided by third parties. Unless expressly labeled or annotated as “raw-unedited”, Western blot images included in the antibody testing data in our catalog may have been edited, optimized or otherwise adjusted for presentation.
产品信息
17449-1-AP
种属反应
已发表种属
宿主/亚型
分类
类型
抗原
偶联物
形式
浓度
规格
纯化类型
保存液
内含物
保存条件
运输条件
产品详细信息
This antibody is a rabbit polyclonal antibody raised against an internal region of human HDAC4. The calculated molecular weight of HDAC4 is 106 kDa, but modified HDAC4 is about 140 kDa.
Immunogen sequence: SKKLLGSLA SVFVRLPCGG VGVDSDTIWN EVHSAGAARL AVGCVVELVF KVATGELKNG FAVVRPPGHH AEESTPMGFC YFNSVAVAAK LLQQRLSVSK ILIVDWDVHH GNGTQQAFYS DPSVLYMSLH RYDDGNFFPG SGAPDEVGTG PGVGFNVNMA FTGGLDPPMG DAEYLAAFRT VVMPIASEFA PDVVLVSSGF DAVEGHPTPL GGYNLSARCF GYLTKQLMGL AGGRIVLALE GGHDLTAICD ASEACVSALL GNELDPLPEK VLQQRPNANA VRSMEKVMEI HSKYWRCLQR TTSTAGRSLI EAQTCENEEA ETVTAMASLS VGVKPAEKRP DEEPMEEEPP L (623-972 aa encoded by BC039904)
靶标信息
Histone deacetylase 4 (HDAC4) is responsible for the deacetylation of lysine residues on the N-terminal part of the core histones (H2A, H2B, H3, and H4). Histone deacetylation gives a tag for epigenetic repression and plays an important role in transcriptional regulation, cell cycle progression and developmental events. Histone deacetylases act via the formation of large multiprotein complexes. HDAC4 is also involved in muscle maturation via its interaction with the myocyte enhancer factors such as MEF2A, MEF2C and MEF2D. It is also involved in the MTA1-mediated epigenetic regulation of ESR1 expression in breast cancer. Mutations to the HDAC4 gene have been found in Brachydactyly-mental retardation syndrome (BDMR).
仅用于科研。不用于诊断过程。未经明确授权不得转售。
生物信息学
蛋白别名: DKFZp779K1053; HD4; HD7; HD7b; HD9; HDAC; HDAC7; HDAC7B; HDAC9; HDAC9B; HDAC9FL; HDRP; Histone deacetylase 4; KIAA0744; MITR
基因别名: HDAC4; KIAA0288
Entrez Gene ID: (Human) 9759